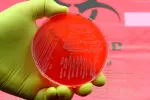
Un plato de Petri con un cultivo de la bacteria Acinetobacter baumannii

Medicamentos
Te presentamos la información más completa en forma de prácticas y sencillas guías sobre los medicamentos de uso más común, cómo tomarlos, sus interacciones con el alcohol o el embarazo, precauciones y posibles efectos secundarios.
Más noticias de Medicamentos
-

Crean un antibiótico súper asesino para matar bacterias multirresistentes
-

Un fármaco para la adicción a la cocaína podría tratar el cáncer de colon
-

Un fármaco para el cáncer podría ayudar a tratar también el párkinson
-

Fármacos para tratar la disfunción eréctil reducen el riesgo de alzhéimer
-

Los científicos codifican ChatGPT para diseñar nuevos medicamentos
-

España financiará nivolumab para el tratamiento del cáncer de pulmón
-

Crean un método para administrar insulina a diabéticos por vía oral
-

Italfarmaco recibe la aprobación de la FDA para exportar sus medicamentos
-

Nueva terapia mejora el tratamiento para erradicar Helicobacter pylori
-

La hidroxicloroquina contra el COVID causó miles de muertes en España
-

El antibiótico Zosurabalpina puede eliminar una superbacteria mortal
-

Fármaco antidiabético evita que las mujeres engorden si dejan de fumar
-

Europa aprueba Mounjaro, que promete reducir un 20% el sobrepeso
-

España financiará el primer fármaco para tratar la huérfana hepatitis D
-

Los nuevos fármacos para adelgazar: mejor avance científico de 2023
-

Los pacientes obesos recuperan mucho peso cuando dejan de tomar Zepbound
Especial informativo
Entrevistas relacionadas
-

José Carlos Bouso
José Carlos Bouso
Psicólogo y doctor en Farmacología Clínica, experto en psicodélicos y autor de ‘Medicina psiquedélica’ -

Dra. Esther Samper
Dra. Esther Samper
Dra. en Ingeniería Tisular Cardiovascular, máster en Biotecnología, médica y autora de ‘El lado oscuro de la farmacia’ -

Mariano Esteban
Mariano Esteban
Investigador y virólogo español, jefe del Grupo de Poxvirus y Vacunas del Centro Nacional de Biotecnología del CSIC -

Carme Valls Llobet
Carme Valls Llobet
Política, médica experta en endocrinología y perspectiva de género y autora de ‘Mujeres invisibles para la medicina'